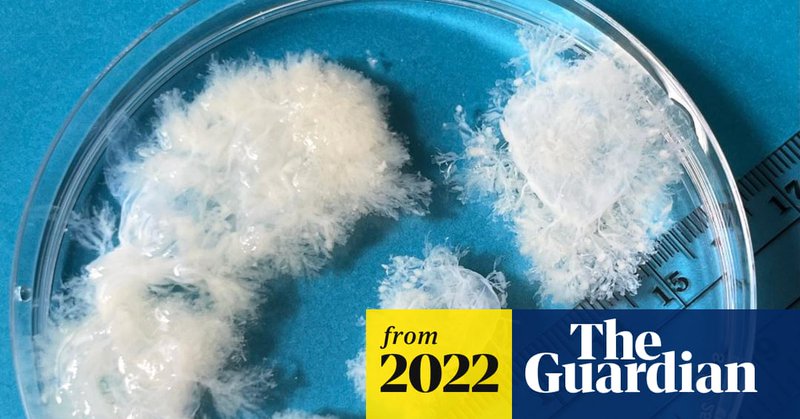
Tweet card summary image

Dr Dr Jolene Galbreath 🇳🇱
@dr_galbreath
Followers
720
Following
13K
Media
803
Statuses
8K
Anaesthetic CF, trainee rep of @healthwatch_uk, once-upon-a-time biologist, physiological engineer. On the hunt for a time turner. ☕️🚴♀️🏊♀️
Joined February 2012
I am already thinking about how I might make it to #SOA24 in Liverpool, both in terms of study budget and leave and actually cycling the double distance of 680km round trip.
0
0
2
Reflecting on #SOA23 @ICS_updates. I cycled 376km round trip, one of 3 attendees to have ridden their Bikes to Brum. My poster was well received and there were some excellent sessions. It was an inspiring week and the social event was just what the doctor ordered.
3
0
6
Hi @GaslingSarah! Just saw the upcoming webinar that you are organising! Prompted me to download Twitter to say ‘how are ya?’ And also, ‘the webinar looks great!’ And also, ‘st4, yay! You have a reg number! Woohoo!’ And finally, ‘how’s life on the bike?’
1
0
1
A team of British cycleball players, all from the South Region, will make their country’s first appearance at the UCI Indoor Cycling World Championships - the first time against 11 other nations in Ghent this November. Read more 👇 https://t.co/R4ggEdUYvw
0
3
10
🤷🏼♂️ What is Cycle-ball? Well, in a nutshell - 2 🆚 2 football on bikes! Bernd (and his cousin, Gerhard) are legends of the game, guiding Germany to the World Championship in 2021. We caught up with him as he limbered up for this year's World Champs in Ghent! #Ghent2022
0
3
8
What a pregnancy actually looks like at nine weeks – in pictures What a great project. The gap between what we think we know and what is reality can be so large. We can be worried or anxious and a bit more knowledge can make all the difference.
theguardian.com
In 13 US states, abortion is banned even in the earliest stages of pregnancy. But we rarely see what such tissue really looks like
0
0
0
Mostly a break for mostly a year…there have been some middle of the night postings and the occasional article. But, had not felt quite in a place where I could use Twitter while being able to resist the pull of doom scrolling.
0
0
0
I’ve been off Twitter for a year. Needed the break to get through exam revision. Tempted back by the education and sharing of best practice. And, of course, to see my own face smiling back at me 😉
1
0
9
Feels like home is becoming the only safe food space.
0
0
0
One of our kids is afraid to make their own food choices for fear of becoming fat. They have a normal body size and yet have already internalised that their worth will be measured by their size by society. The calories on menus has made it worse, too.
1
0
0
But, at least at school it wasn’t being rammed down our throats as well. We have tried our darnedest to do better by our kids but they are still affected by our struggles. What I had not counted on was the impact the messages from school and the government would have.
1
0
0
My aunties used to reach out to my tummy when I was a young teen and ‘pinch an inch’ and comment on my size. I was normal. But the ‘chubbiest’ of the cousins. All of them were eternally dieting. All of my generation have complicated relationships with food and our bodies.
1
0
1
‘Alarming’ rise in children trying to lose weight in England, say experts Sorry, but no sh*t Sherlock. The emphasis on obesity and the fat phobic way we talk about food and weight is incredibly damaging.
theguardian.com
Research suggests one in four children are on diets, including one in seven who are considered a healthy weight
1
0
0
Female pilots finally celebrated for crucial role in Battle of Britain
theguardian.com
Pioneering female aviators delivered planes wherever they were needed in the second world war – armed with just a notebook
0
0
0
Here’s why people cycling two abreast is actually better for people driving motor vehicles. It’s quite simple really.
392
2K
8K
Good to see @RCObsGyn statement, & that abortion rights activists are fighting back all over the world since Roe v. Wade was overturned. Here is the #WorldtoUS open letter too #RoeVWade
secure.avaaz.org
People from all over the world are signing this open letter that says …
0
5
10
And it’s my third use of the word this morning: Disappointing. In the @bmj_latest on @TheBMA all male shortlists for top roles. Link here if preferred: https://t.co/GHF6q7asih
1
3
4
We have joined over 100 global healthcare organisations including @FSRH_uk, @FIGOHQ and @ACOG in condemning the decision by the US Supreme Court. Find out more: https://t.co/I0KBbOQoLj View the joint statement: https://t.co/fCjKtKtN71
#RoeVsWade
9
341
799
I've posted b4 abt our son James - he's 15, he's autistic & he's brilliant. After long training, at 13.02 we're now starting the 70-mile Cumbria Way to fundraise so more autistic people can learn to swim. Pls put a spring in our step and donate, if you can https://t.co/YbPCxamsrj
14
95
667